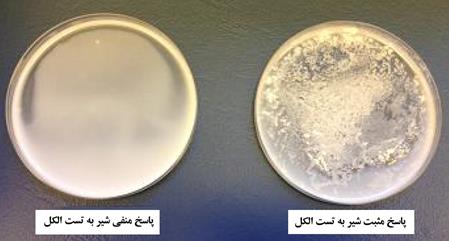

به گزارش «سرویس آموزشی» «ماکی دام - پایگاه خبری صنعت دام، طیور و آبزیان»؛ تست الکل آزمونی است که معمولاً در مبادی ورودی کارخانههای شیر و فرآوردههای لبنی آن انجام میگیرد. این تست نشاندهندهی میزان پایداری پروتئینهای شیر به فرآوری گرمایی است، زیرا شیر چه به صورت خام و چه به صورت فرآوری شده برای عرضه به بازار گرما داده میشود (مانند پاستوریزاسیون، استرلیزاسیون، تولید شیر خشک، تولید ماست و...)
مثبت بودن تست الکل برای یک نمونهی شیر به معنای ناپایداری آن به حرارت دادن و کاهش شدید کیفیت شیر برای فرآوری خواهد بود. این تست برای سنجش وضعیت اسیدیته شیر نیز کاربرد دارد. این تست نخستین بار توسط Eugling در سال 1909 ابداع شد و بعدها (سال 1932) توسط Fleischmann و Martiny به شکل امروزی در آمد. Eugling متوجه شد که وقتی مقادیر مساوی از شیر و الکل اتانل 95درصد با هم مخلوط شوند، کازئین شیر لخته شده و رسوب میکند. با این روش ساده میتوان به سرعت، به تازگی و یا غیرطبیعی بودن شیر پی برد. این روش حتی برای شیرهای تغلیظ شده (Condensed milk) نیز قابل استفاده است. شیری که نسبت به تست الکل، پاسخ مثبت میدهد، جزو شیرهای درجه 2 دستهبندی شده و معمولاً بیشتر برای کرهسازی قابل استفاده بوده و یا در صورت پایین بودن شدید کیفیت، کلاً برگشت داده میشود.
آغوز، شیر دوشیده شده در پایان شیردوشی، و یا شیر ورم پستانی (و یا هر بیماری عفونی دیگر) به تست الکل پاسخ مثبت میدهند. شیر گاوهایی که از سیلوی کپکزده تغذیه کرده باشند نیز به تست الکل پاسخ مثبت میدهند. حتی در برخی موارد، ممکن است شیر کاملاً سالم نیز به تست الکل پاسخ مثبت دهد.
تست الکل بر اساس تمایل شیر به ناپایدار شدن در نتیجه بههم خوردن تعادل مواد معدنی در شیر میباشد. در صنعت شیر از سه غلظت گوناگون برای انجام تست الکل استفاده میشود:
- الکل 68 درصد حجمی/حجمی در آب؛
- الکل 65 درصد حجمی/حجمی در آب؛
- الکل 60 درصد حجمی/حجمی در آب؛
بیشتر بدانیم:
10 راه عملی در کاهش ورم پستان و بهبود کیفیت شیر با صرف کمترین وقت
بهداشت دستگاه شیردوش و جایگاه شیردوشی
شیر خام نخورید
شیری که تست الکل 68درصد را با موفقیت (به اصطلاح) پاس کند، دارای بالاترین کیفیت است. برای تولید شیرخشک و شیر UHT (Ultra-high temperature milk ، گرمادهی شیر با دمای بیش از 135درجه سلسیوس)، پاس کردن تست الکل 68درصد ضروری است. برای محصولات شیری که نیاز به گرمادهی شدید ندارد (مانند پاستوریزاسیون)، منفی بودن تست الکل 60درصد ضروری است. اگر شیری نتواند تست الکل 60درصد را پاس کند (یعنی به تست الکل 60درصد پاسخ مثبت دهد)، از سوی کارخانههای شیر برگشت داده میشود.
روش کار تست الکل بسیار ساده است: 5 میلیلیتر شیر خام با 5 میلیلیتر محلول اتانول (60 ، 65 ، یا 68 درصد حجمی/حجمی) در دمای اتاق مخلوط، و پس از 10 دقیقه نتیجه آزمایش مورد بررسی قرار میگیرد. اگر شیر دارای کیفیت مناسبی باشد، منعقد نخواهد شد. تشکیل رسوب یا دلمه نشاندهنده مثبت بودن تست، و بیکیفیت بودن شیر است.
دلیل برگشت دادن شیر توسط کارخانه آن است که شیری که به تست الکل پاسخ مثبت بدهد، به سرعت در اثر فرآیند گرمایی، لخته و دلمه میشود. این لخته یا دلمه شدن در طی فرآیند گرمایی، سبب رسوب شیر در مخازن و لولههای انتقال شیر و نیز دیگر تجهیزات شده و به بدین ترتیب خط تولید فرآوردههای شیری را مختل و بعضاً به کلی از کار میاندازد (شکل 1 و 2)
برای جلوگیری از مثبت شدن تست الکل در شیر (که نشاندهنده کیفیت پایین شیر است) باید موارد زیر را رعایت کرد:
- شیردوشی از گاوهای سالم؛
- رعایت اصول بهداشتی به هنگام شیردوشی؛
- مهارت کارگر شیردوش؛
- سرد کردن شیر بلافاصله پس از شیردوشی؛
- جلوگیری از ورود آغوز به مخزن شیر؛
- جلوگیری از دوشش بیش از حد پستان (جلوگیری از ورود شیر حاصل از پایان شیردوشی به مخزن شیر)؛
- جلوگیری از ورود شیر گاوهای بیمار و ورم پستانی به مخزن شیر.
حتی با وجود رعایت موارد بالا، باز هم برخی شیرهای سالم نسبت به تست الکل پاسخ مثبت میدهند. یکی از دلایل اصلی بروز چنین حالتی، عدم تعادل یونها در شیر است. افزایش یونهای کلسیم و منیزیم در شیر سبب افزایش احتمال لخته شدن پروتئینهای شیر در حضور الکل میشود. در این میان تأثیر کلسیم و فسفات از بقیه یونها بیشتر است. در واقع حساسیت شیر طبیعی به لخته شدن در برابر الکل بستگی زیادی به محتوای خاکستر شیر به ویژه تعادل کلسیم و فسفات دارد.

1- شیر خام نرمال، پس از گرمادهی و جوشیدن و سپس سرد شدن، رسوب یا دلمهای در آن ایجاد نشده است (این شیر به تست الکل 68درصد پاسخ منفی داده و دارای کیفیتی بالا است).
2- شیر خامی که پس از جوشیدن و سپس سرد شدن، رسوب یا دلمههای اندکی در پیرامون آن ایجاد میشود (این شیر به تست الکل 68درصد پاسخ مثبت، و به تست الکل 60درصد پاسخ منفی میدهد. این شیر برای فرآیندهای با گرمادهی متوسط مانند پاستوریزاسیون مناسب است، ولی گرمادهی بالا را تحمل نکرده و رسوب میدهد).
3- شیر خامی که پس از جوشیدن و سپس سرد شدن، کاملاً رسوب و دلمه ایجاد میکند. این شیر به تست الکل 60درصد پاسخ مثبت میدهد و به وسیله کارخانههای شیر، برگشت داده میشود.
در زیر به بررسی عوامل تأثیرگذار بر پاسخ شیر به تست الکل پرداخته میشود:
1- اثر نژاد گاو بر حساسیت شیر به تست الکل: پژوهشها نشان دادهاند که نژاد گاو هیچ ارتباطی با پاسخ شیر به تست الکل ندارد؛
2- اثر مرحله شیردهی (Lactation period) بر حساسیت شیر به تست الکل: آغوز (نخستین شیر تولیدی توسط پستان) به شدت به تست الکل پاسخ مثبت میدهد. احتمال پاسخ مثبت شیر تولیدی در اواخر دوره شیردهی نیز به تست الکل بالا است. در طول دوره شیردهی، پاسخ شیر به تست الکل بستگی به دیگر عوامل ذکر شده در بخشهای زیر دارد؛
3- اثر یونها بر حساسیت شیر به تست الکل.
تغییر یونهای معدنی در شیر روی پاسخ آن به تست الکل مؤثر است. محتوای خاکستر آغوز و نیز شیر در پایان دوره شیردهی بالاتر از شیر نرمال است. مقدار یون کلر در آغوز کمتر از شیر است ولی با گذشت زمان مقدار آن بهتدریج افزایش مییابد. میزان Ca و Mg در آغوز و نیز شیر در پایان دوره شیردهی بیشتر از شیر نرمال است. افزایش کلسیم و منیزیم به بیشازحد نرمال سبب بالا رفتن احتمال مثبت شدن تست الکل شیر میشود. احتمال مثبت شدن تست الکل در شیر گاومیش بیشتر از شیر گاو است، زیرا مقدار کلسیم شیر گاومیش بیشتر از شیر گاو است.
مقدار سدیم و فسفر در کل دوره شیردهی تقریباً ثابت است ولی میزان پتاسیم در شیر نرمال بیشتر است. شیرهایی که به تست الکل پاسخ مثبت میدهند معمولاً دارای محتوای خاکستر، کلسیم، منیزیم و کلر بیشتری هستند (نسبت به شیرهایی که به این تست پاسخ منفی میدهند). برعکس، چنین شیرهایی (با پاسخ مثبت به تست الکل) دارای مقدار پتاسیم و فسفر کمتری هستند. افزایش فسفر شیر نقش مهمی در کاهش حساسیت آن به تست الکل میشود. در مجموع احتمال مثبت شدن تست الکل در آغوز و شیر پایان دوره شیردهی بیشتر از شیر نرمال است.
هرچه ظرفیت کاتیونهای شیر بیشتر باشد، احتمال پاسخ مثبت شیر به تست الکل بیشتر است. بهعنوان نمونه، ترتیب زیر در افزایش احتمال پاسخ مثبت شیر در تست الکل وجود دارد:
سدیم (تک ظرفیتی) < کلسیم (دو ظرفیتی) < آهن (سه ظرفیتی)
بنابراین میتوان نتیجه گرفت که افزایش یونهایی مانند آهن و کلسیم در شیر سبب افزایش حساسیت آن به تست الکل میشود. توجه به این نکته ضروری است که در صورتی که میزان کاتیونهای دو یا سهظرفیتی در شیر بالا باشد، ولی مقدار کاتیونهای تکظرفیتی نیز در شیر افزایش داده شود، حساسیت شیر به تست الکل کاهش مییابد. بهعبارت دیگر، کاتیونهای تک ظرفیتی سبب کاهش اثر کاتیونهای دو یا سه ظرفیتی در مستعد کردن شیر به پاسخ مثبت به تست الکل میشود.
در مجموع کاتیونهای تکظرفیتی تأثیر خاصی روی حساسیت شیر به تست الکل ندارند ولی افزایش غلظت کاتیونهای دو و به ویژه سهظرفیتی (مانند آهن) سبب افزایش حساسیت شیر به تست الکل میشود. در شیرهای ورم پستانی نیز به دلیل عدم تعادل به وجود آمده در تعادل یونها، تست الکل مثبت خواهد شد؛
4- دمای شیر نیز در میزان حساسیت آن به تست الکل مؤثر است. دماهای خیلی بالا (بیش از 50 درجه سلسیوس) یا خیلی پایین سبب کاهش احتمال مثبت شدن تست الکل میشود. بیشترین احتمال مثبت شدن تست الکل شیر در دماهای میان 15 تا 20 درجه سلسیوس است. افزایش دما به بیش از 20 درجه سلسیوس سبب کوتاه شدن زمان تشکیل لخته در شیر میشود. انجماد و ذوب مجدد شیر موجب افزایش اندکی در حساسیت آن به تست الکل میشود؛
5- نور سبب اکسیداسیون ترکیبات شیر به ویژه چربیهای آن شده و بدین ترتیب موجب مثبت شدن تست الکل شیر میشود؛
6- افزایش پروتئینهای سرمی شیر (به ویژه در شیرهای ورم پستانی یا آغوز) ممکن است سبب مثبت شدن تست الکل شیر شود؛
7- افزایش بار میکروبی شیر و بالا رفتن اسیدیته شیر (کاهش pH شیر) به دلیل بروز تخمیرهای اسیدی موجب مثبت شدن تست الکل شیر آلوده میشود؛
8- افزودن آب به شیر سبب افزایش زمان تشکیل دلمه در آن شده و بدین ترتیب زمان لازم برای مثبت شدن تست الکل را افزایش میدهد.
تهیه و تدوین: دکتر محمد چمنی